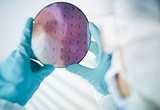

-

인피니언, 전력반도체 공급 위한 말레이시아 신규 팹 '첫 걸음'
- 2024-08-08 15:23
- 서재창 기자
-

웨이퍼 출하량, 30억3500만in²로 1분기 대비 7% 증가
- 2024-08-05 15:32
- 서재창 기자
-

SEMI “반도체 생산능력 증가, AI 반도체 수요에 대응할 것“
- 2024-06-24 14:07
- 서재창 기자
-

온세미, 3분기 실적 자동차 부문 전년 대비 33% 증가
- 2023-11-01 13:37
- 이동재 기자
-

TI, 친환경 설계 반영된 팹 'RFAB2'로 LEED 골드 등급 획득
- 2023-09-04 12:37
- 서재창 기자
-

ADI, 오리건주 반도체 웨이퍼 팹 확장 위해 10억 달러 투자
- 2023-07-28 14:46
- 서재창 기자
-

'보조금이냐 중국 시장이냐' 선택 기로 놓인 삼성·SK
- 2023-02-24 14:58
- 서재창 기자
-

인피니언, 독일 드레스덴에 신규 팹 착공...반도체 수요 충족할 것
- 2023-02-18 20:09
- 함수미 기자
-

TI, 유타주에 300mm 반도체 웨이퍼 제조공장 건설 계획 밝혀
- 2023-02-17 09:51
- 서재창 기자
-

온세미, 글로벌파운드리 EFK 팹 인수로 경쟁력 확보
- 2023-02-14 13:33
- 서재창 기자
-

용인 반도체 클러스터, 내달 착공식 예정...3년 만에 '첫 삽'
- 2022-06-22 22:32
- 서재창 기자
-

바이코, 최첨단 팹 설립으로 전력 모듈 고도화 개발 속도낸다
- 2022-05-24 14:24
- 서재창 기자
-

TI, 텍사스주서 반도체 웨이퍼 제조 공장 착공식 개최해
- 2022-05-19 14:07
- 서재창 기자
-

인피니언, 쿨림 공장 추가 건설로 전력 반도체 시장 주도한다
- 2022-02-21 09:38
- 서재창 기자
-

네패스, 팹 준공으로 차세대 패키징 공정 'FOPLP' 양산 돌입
- 2021-12-08 16:17
- 서재창 기자
-

최태원 SK 회장, “美 반도체 생산공장은 아직 검토 단계”
- 2021-12-07 10:37
- 서재창 기자
-

TI, 내년도 텍사스 셔먼에 웨이퍼 제조공장 설립 예정
- 2021-11-18 09:12
- 서재창 기자
-

인피니언, 300mm 웨이퍼 생산하는 첨단 공장 가동한다
- 2021-09-28 09:51
- 서재창 기자
-

2008년 금융위기 후 반도체 팹 폐쇄 '상승' 향후 코로나19 영향 클까?
- 2020-04-02 15:23
- 이나리 기자